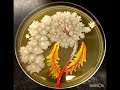
Link wray - Vendetta

Help
Click on the album cover or album title for detailed infomation
or select an online music provider to listen to the MP3.
New on songlist - Song videos!! Click on the video thumbnails to go to the videos page.
New on songlist - Song videos!! Click on the video thumbnails to go to the videos page.